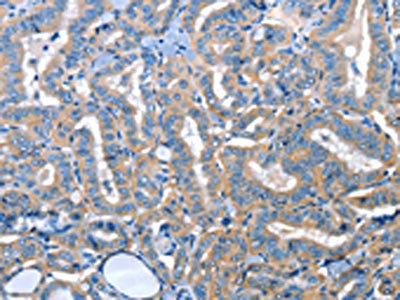

ADH4 Antibody
-
中文名稱:ADH4兔多克隆抗體
-
貨號(hào):CSB-PA408174
-
規(guī)格:¥1100
-
圖片:
-
The image on the left is immunohistochemistry of paraffin-embedded Human thyroid cancer tissue using CSB-PA408174(ADH4 Antibody) at dilution 1/25, on the right is treated with fusion protein. (Original magnification: ×200)
-
The image on the left is immunohistochemistry of paraffin-embedded Human lung cancer tissue using CSB-PA408174(ADH4 Antibody) at dilution 1/25, on the right is treated with fusion protein. (Original magnification: ×200)
-
-
其他:
產(chǎn)品詳情
-
Uniprot No.:
-
基因名:ADH4
-
別名:Ac1002 antibody; ADH 4 antibody; ADH-1 antibody; ADH-2 antibody; ADH2 antibody; Adh4 antibody; ADH4_HUMAN antibody; Alcohol dehydrogenase 4 (class II) pi polypeptide antibody; Alcohol dehydrogenase 4 antibody; Alcohol dehydrogenase class II pi chain antibody; Alcohol dehydrogenase pi isozyme ADH class II antibody; Aldehyde reductase antibody; Class II alcohol dehydrogenase 4 pi subunit antibody
-
宿主:Rabbit
-
反應(yīng)種屬:Human
-
免疫原:Fusion protein of Human ADH4
-
免疫原種屬:Homo sapiens (Human)
-
標(biāo)記方式:Non-conjugated
-
抗體亞型:IgG
-
純化方式:Antigen affinity purification
-
濃度:It differs from different batches. Please contact us to confirm it.
-
保存緩沖液:-20°C, pH7.4 PBS, 0.05% NaN3, 40% Glycerol
-
產(chǎn)品提供形式:Liquid
-
應(yīng)用范圍:ELISA,IHC
-
推薦稀釋比:
Application Recommended Dilution ELISA 1:2000-1:5000 IHC 1:25-1:100 -
Protocols:
-
儲(chǔ)存條件:Upon receipt, store at -20°C or -80°C. Avoid repeated freeze.
-
貨期:Basically, we can dispatch the products out in 1-3 working days after receiving your orders. Delivery time maybe differs from different purchasing way or location, please kindly consult your local distributors for specific delivery time.
-
用途:For Research Use Only. Not for use in diagnostic or therapeutic procedures.
相關(guān)產(chǎn)品
靶點(diǎn)詳情
-
功能:Catalyzes the NAD-dependent oxidation of either all-trans-retinol or 9-cis-retinol. Also oxidizes long chain omega-hydroxy fatty acids, such as 20-HETE, producing both the intermediate aldehyde, 20-oxoarachidonate and the end product, a dicarboxylic acid, (5Z,8Z,11Z,14Z)-eicosatetraenedioate. Also catalyzes the reduction of benzoquinones.
-
基因功能參考文獻(xiàn):
- Association between HCRTR2, ADH4,CLOCK gene polymorphisms and cluster headache was not significant in the present study. PMID: 29318394
- this current study provides substantial evidence that genetic polymorphisms of rs3805322 in the ADH4 gene may be associated with an increased risk of developing ESCC in two Chinese Han populations. PMID: 26039424
- This study confirmed the genetic heterogeneity of cluster headache, suggesting that mutations in the ADH4 gene might be related to cluster headache in a subset of cases. PMID: 24469609
- The serum expression of ADH4 protein correlates with the progression of esophageal cancer. PMID: 24051444
- expression levels of ADH4 mRNA and protein have found to be markedly reduced in hepatocellular carcinoma (HCC) tissues and significantly associated with survival. PMID: 22147505
- data suggest that ADH4 intronic variants play a role in alcohol dependence susceptibility in Italian populations PMID: 22044940
- Our results suggest that the analysed polymorphisms ofANKK1 and ADH4 can play an important part in the pathogenesis of alcohol abuse PMID: 22232963
- the high catalytic activity of human alcohol dehydrogenase 4 studied with horse liver ADH1E PMID: 21184752
- This study confirms the significant relationship of ADH4 variants with AD and related phenotypes. PMID: 20626721
- Data indicate that further studies of EPHX1 rs1051740, ADH4 r1042364, and NQO1 rs291766 are needed to make more definitive conclusion on the role of variation in xenobiotic metabolism in ovarian cancer. PMID: 21480392
- Our data suggest that cluster headache is associated with the ADH4 gene or a linked locus. Additional studies are warranted to elucidate the role of this gene in the etiopathogenesis of the disease. PMID: 19925625
- In this study we have identified a distal upstream enhancer, 4E, of ADH4. In HepG2 human hepatoma cells, 4E increased the activity of an ADH4 basal promoter by 50-fold. 4E was cell-specific. PMID: 20363298
- ADH4 gene polymorphisms are associated with upper aerodigestive tract cancers. PMID: 19861527
- Thirteen new single nucleotide polymorphisms PMID: 11916005
- Identification and characterisation of two allelic forms of human alcohol dehydrogenase 2 PMID: 11964133
- kinetic mechanisms for ADH4 functioning as retinol dehydrogenase PMID: 11997393
- Results describe the expression patterns of alcohol dehydrogenases I, III, and IV in adult rat, mouse and human tissues using radioactive oligonucleotide in situ hybridization. PMID: 12631290
- The mean alcohol-elimination rate among ADH2*2 carriers is significantly higher than among ADH2*1 homozygotes in a male Jewish population. PMID: 14745297
- the genotypes of six ADH4 markers were associated with alcohol dependence, and all seven ADH4 markers were associated with drug dependence PMID: 16220108
- Seven single nucleotide polymorphisms spanning the ADH4 gene were genotyped in 561 subjects affected with alcohol dependence and/or drug dependence. PMID: 16237392
- that personality traits and substance dependence have a partially overlapping genetic basis. PMID: 17069770
- Class II alcohol dehydogenase (ADH4) is considered to contribute to ethanol oxidation in the liver at high concentration. PMID: 19182438
顯示更多
收起更多
-
亞細(xì)胞定位:Cytoplasm.
-
蛋白家族:Zinc-containing alcohol dehydrogenase family, Class-II subfamily
-
數(shù)據(jù)庫(kù)鏈接:
Most popular with customers
-
-
YWHAB Recombinant Monoclonal Antibody
Applications: ELISA, WB, IHC, IF, FC
Species Reactivity: Human, Mouse, Rat
-
Phospho-YAP1 (S127) Recombinant Monoclonal Antibody
Applications: ELISA, WB, IHC
Species Reactivity: Human
-
-
-
-
-